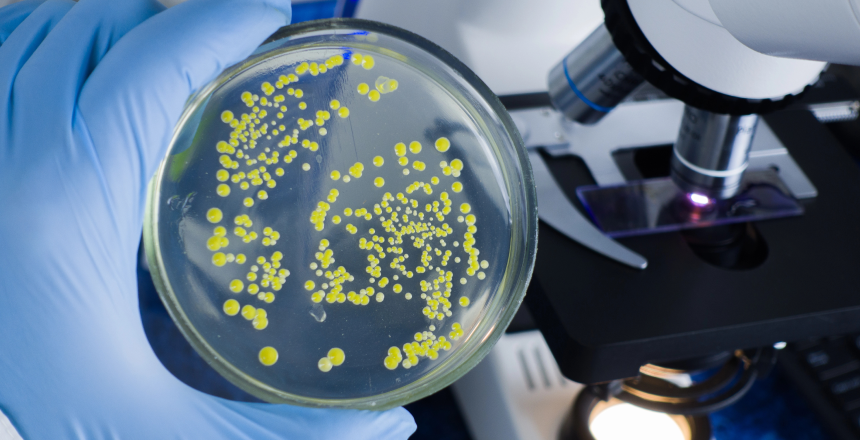

Для перегляду доступних досліджень та термінів їх виконання

Золотистий стафілокок
Створено: 03.02.2025- Вступ
- Що таке золотистий стафілокок?
- Як виглядає золотистий стафілокок?
- Як передається золотистий стафілокок?
- Чим небезпечний золотистий стафілокок? (штам MRSA, VRSA, GISA)
- Основні захворювання, спровоковані золотистим стафілококом
- Діагностика золотистого стафілокока
- Норма золотистого стафілококу
- Золотистий стафілокок у дітей та немовлят
- Сучасні методи лікування золотистого стафілококу
- Як уникнути зараження золотистим стафілококом? – поради для збереження Вашого здоров'я від ДІЛА
Вступ
Інфекції оточують нас повсюди – вдома, на роботі, у транспорті. Більшість із них ми навіть не помічаємо завдяки міцному імунітету, але існують мікроорганізми, здатні скористатися будь-якою слабкістю організму та викликати серйозні захворювання. Одним з таких мікроорганізмів є золотистий стафілокок (Staphylococcus aureus).
Що таке золотистий стафілокок?
Золотистий стафілокок – це бактерія сферичної форми, яка належить до роду стафілококів. Вона отримала свою назву через золотистий колір колоній, які утворюються під час її вирощування на поживних середовищах. Насправді бактерія може бути частиною нормальної мікрофлори шкіри й слизових оболонок, проте за певних умов стає небезпечною для здоров’я. Симптоми золотистого стафілококу залежать від місця ураження бактерією.
Як виглядає золотистий стафілокок?
За розміром діаметр золотистого стафілококу становить приблизно 0,5–1,5 мікронів. Під мікроскопом бактерії утворюють скупчення, які нагадують грона винограду, що й дало назву цій групі мікроорганізмів.
На поживних середовищах золотистий стафілокок утворює колонії золотисто-жовтого кольору (завдяки пігменту каротиноїду). Саме ця особливість допомагає ідентифікувати його в лабораторії. Бактерія має товсту клітинну стінку, яка забезпечує їй стійкість до несприятливих умов навколишнього середовища, а також виробляє токсини і ферменти, що сприяють її патогенності.
Як передається золотистий стафілокок?
Золотистий стафілокок має високу здатність до поширення і саме це робить його однією з найпоширеніших інфекцій у світі.
Звідки береться золотистий стафілокок? До основних шляхів передачі належать:
- Контактно-побутовий шлях – найпоширеніший спосіб зараження. Бактерія передається через рукостискання або дотик до шкіри інфікованої людини; через забруднені предмети побуту, такі як рушники, іграшки, дверні ручки, мобільні телефони; рани, порізи або тріщини на шкірі, через які бактерія легко проникає в організм.
- Повітряно-крапельний шлях – під час кашлю, чхання або розмови інфікованої людини мікроскопічні краплі зі стафілококом потрапляють у повітря і осідають на слизових оболонках чи шкірі здорової людини.
- Аліментарний шлях – через вживання їжі, зараженої стафілококом або його токсинами. Найчастіше це молочні продукти, кондитерські вироби (торти, тістечка з кремом), м’ясні та рибні продукти, які зберігались у неналежних умовах.
- Медичний шлях – під час процедур, якщо не дотримано правил стерильності. Особливо це стосується ін’єкцій, хірургічних втручань та встановлення катетерів або протезів.
Золотистий стафілокок так легко передається через його високу стійкість до зовнішніх умов. Бактерія здатна виживати на різних поверхнях протягом тривалого часу, не втрачаючи своєї активності, а також стійка до змін температури, висихання та деяких дезінфекційних засобів, що ускладнює боротьбу з її поширенням.
Чим небезпечний золотистий стафілокок? (штам MRSA, VRSA, GISA)
Золотистий стафілокок є небезпечною бактерією через свою високу здатність викликати інфекції та розвивати стійкість до антибіотиків. Особливу небезпеку становлять стійкі штами золотистого стафілокока, які ускладнюють лікування і підвищують ризик важких ускладнень.
До основних штамів, які є стійкими до антибіотиків належать:
- MRSA (метицилін резистентний золотистий стафілокок) – штам, шо є нечутливим до більшості β-лактамних антибіотиків. Він часто стає причиною внутрішньолікарняних інфекцій. Зараження MRSA може відбуватися під час хірургічних втручань, через рани, використання катетерів або навіть при тривалому контакті з інфікованими поверхнями. Інфекції MRSA складно лікувати і вони є небезпечними, адже можуть прогресувати в абсцеси, пневмонію чи навіть сепсис.
- VRSA (ванкоміцин-резистентний Staphylococcus aureus) – штам золотистого стафілокока, який характеризується стійкістю до ванкоміцину. Цей тип досить рідко зустрічається, але є найбільш небезпечним. Його резистентність до найефективнішого антибіотика значно ускладнює лікування та збільшує ризик смертельних ускладнень.
- GISA (глікопептид-інтермедіарний Staphylococcus aureus) – штам, якому характерна проміжна стійкість до глікопептидних антибіотиків (ванкоміцин, тейкопланін). GISA може виникати у пацієнтів із тривалими госпіталізаціями або частим застосуванням антибіотиків. Він вимагає використання комбінації препаратів і тривалого лікування.
Основні захворювання, спровоковані золотистим стафілококом
Золотистий стафілокок може викликати багато захворювань, що залежать від місця проникнення бактерії в організм. Від локальних інфекцій до серйозних хронічних станів – бактерія надзвичайно небезпечна своєю здатністю швидко поширюватися та викликати важкі ускладнення.
Інфекції шкіри
Золотистий стафілокок на шкірі є однією з найпоширеніших причин її гнійно-запальних захворювань. Бактерія проникає через пошкодження шкірного бар'єру, викликаючи:
- стафілококовий фолікуліт — запалення волосяних фолікулів, що проявляється почервонінням, свербінням та гнійними висипаннями на шкірі;
- імпетиго – поверхневе ураження шкіри (стафілококова висипка) з утворенням пухирців, які розриваються, залишаючи кірки;
- абсцеси – глибокі гнійні утворення, які вимагають хірургічного втручання
Інфекції шкіри можуть супроводжуватися лихоманкою та загальною слабкістю, особливо у випадках важкого перебігу.
Також може бути вагінальний стафілокок, що спричиняє запалення та інфекції жіночих статевих органів.
Стафілококовий синдром обпеченої шкіри
Стафілококовий синдром обпеченої шкіри (SSSS) – це досить рідкісний, але серйозний стан, який спричиняють токсини, вироблені золотистим стафілококом. Вони руйнують зв’язки між клітинами епідермісу, що призводить до відшарування верхнього шару шкіри.
До основних симптомів стафілококового синдрому обпеченої шкіри належать почервоніння, схожі на опік, та утворення пухирів, які відшаровуються при дотику.
SSSS частіше вражає шкіру немовлят та дітей через слабку імунну систему.
Золотистий стафілокок в горлі (тонзиліт, ангіна та інше)
Золотистий стафілокок може спричиняти і захворювання горла, серед яких:
- стафілококовий тонзиліт – це запалення мигдаликів, для якого характерний біль, почервоніння і набряк;
- стафілококова ангіна – гнійне ураження горла з нальотом на мигдаликах, що супроводжується високою температурою та болем при ковтанні.
Інфекція часто супроводжується загальною слабкістю, збільшенням лімфовузлів, ускладненням дихання. У разі відсутності лікування бактерія може поширитися на інші органи.
Золотистий стафілокок в носі
Стафілокок у носі може проходити безсимптомно, проте при ослабленому імунітеті здатен викликати:
- риніт – запалення слизової носа із закладеністю, виділеннями та дискомфортом;
- синусит – ураження носових пазух, що супроводжується головним болем, гнійними виділеннями, високою температурою.
Зараження з носа може поширюватися на горло, вуха або потрапляти в кров. Стафілокок у крові може призводити до серйозних інфекцій, таких як сепсис, ендокардит або абсцеси внутрішніх органів.
Стафілококовий отит
Стафілококовий отит – це інфекція середнього вуха, яка часто виникає як ускладнення при поширенні бактерій із носоглотки.
До його основних симптомів належать:
- біль у вусі, що посилюється при натисканні;
- зниження слуху;
- виділення гною з вуха;
- підвищення температури.
Без своєчасного лікування отит може ускладнитися перфорацією барабанної перетинки або поширенням інфекції на внутрішнє вухо.
Харчова стафілококова токсикоінфекція
Харчова токсикоінфекція, спричинена золотистим стафілококом, виникає внаслідок вживання продуктів, забруднених бактеріями або їх токсинами. Цей стан є однією з найпоширеніших причин харчових отруєнь.
Золотистий стафілокок виділяє ентеротоксини – речовини, стійкі до термічної обробки, які не руйнуються при кип’ятінні. Навіть якщо самі бактерії загинули, їх токсини залишаються активними та викликають отруєння.
Основними джерелами зараження, що призводять до стафілококового харчового отруєння є:
- продукти харчування (молочні вироби, м’ясо, яйця, салати з майонезом, кондитерські вироби);
- забруднення їжі через немиті руки кухарів або контакти з інфікованими поверхнями;
- неправильне зберігання продуктів (стафілокок активно розмножується при кімнатній температурі)
При потраплянні в організм токсинів, які виділяє стафілокок також може зʼявитись стафілококовий токсикоз. Він зазвичай супроводжується різким погіршенням самопочуття, нудотою, блюванням і діареєю.
Синдром токсичного шоку
Найважчим ускладненням при інфікуванні золотистим стафілококом є токсичний шок. Він характеризується різким підвищенням температури до критичних значень, нудотою, сильним головним болем, висипом на шкірі та гнійними виділеннями з наявних ран. У таких випадках діагностичні дослідження не проводяться, оскільки цей стан спричиняє виключно золотистий стафілокок.
Окрім цього, фактори ризику розвитку стафілококової інфекції включають використання гігієнічних тампонів з високою абсорбцією, їхнє тривале носіння. Характерними проявами є лихоманка, знижений артеріальний тиск, висип, блювання, діарея та можливий розвиток поліорганної недостатності. Діагностика зазвичай ґрунтується на клінічних симптомах.
Лікування при цих ускладненнях розпочинають негайно, переважно в умовах інтенсивної терапії.
Діагностика золотистого стафілокока
Правильна та своєчасна діагностика золотистого стафілокока є важливою для вибору ефективного лікування та запобігання ускладненням. Діагностика складається з декількох важливих етапів:
- визначення симптомів захворювання
- проведення бактеріологічного дослідження (аналіз на золотистий стафілокок), що складається з посіву біологічних зразків (мазок на стафілокок) для виявлення бактерії
- тестування на чутливість бактерії до антибіотиків, що важливо, адже золотистий стафілокок може бути стійким до деяких ліків, що ускладнює лікування.
У лабораторії ДІЛА ви можете здати Бак. посів на стафілокок (Staphylococcus aureus) одразу з антибіотикограмою ДДМ.
| Назва дослідження | Терміни виконання | Вартість | Додати в кошик |
| Бак. посів на стафілокок (Staphylococcus aureus) з антибіотикограмою ДДМ | 4 дн. | 470 грн | Додати в кошик |
Норма золотистого стафілококу
Золотистий стафілокок може бути присутнім у здорових людей, не викликаючи жодних симптомів інфекції. Тобто, в певних кількостях бактерія може знаходитися на шкірі, слизових оболонках носа, горла або навіть в інших частинах тіла без шкоди для здоров’я. Однак важливо, щоб норма золотистого стафілококу не перевищувала певний рівень, оскільки при зниженні імунітету чи за інших факторів ризику він може стати патогенним.
Норма золотистого стафілокока на шкірі чи слизових оболонках не призводить до інфекційних захворювань. У здорових людей бактерії просто можуть бути присутні у малих кількостях. Проблема виникає у випадках порушення шкірного бар’єру (наприклад, рани, порізи).
Норма стафілококу в носі або норма золотистого стафілокока в горлі має бути мінімальною і при підвищенні рівня бактерії може виникнути ризик розвитку інфекцій.
В лабораторних дослідженнях, як правило, визначають кількість бактерій на певному зразку (наприклад, з мазка або посіву). Наявність золотистого стафілокока в малих кількостях без симптомів захворювання може бути варіантом норми. Однак якщо виявлено великий ріст бактерій або наявність токсинів, це вже є підставою для лікування та подальшого спостереження.
Таким чином, золотистий стафілокок є частиною нормальної мікрофлори організму, але за певних умов (зниження імунітету, травми, хронічні захворювання) він може стати патогенним і викликати інфекцію. Важливо стежити за його кількістю та умовами, що можуть сприяти розвитку захворювань.
Золотистий стафілокок у дітей та немовлят
Діти більш схильні до інфекцій через незрілу імунну систему. Золотий стафілокок у немовлят може викликати серйозні ускладнення, такі як сепсис, синдром обпеченої шкіри чи пневмонія.
Золотистий стафілокок у немовлят в кишечнику, може бути варіантом норми, проте при порушенні балансу мікробіоти або ослабленому імунітеті, здатен викликати серйозні інфекції, такі як гастроентерит, сепсис чи інші ускладнення.
Золотистий стафілокок у немовлят на шкірі може викликати такі інфекції, як піодермія або абсцеси, тому важливо ретельно стежити за станом дитини та своєчасно звертатися до лікаря.
Важливо! Особливо небезпечним є золотистий стафілокок у вагітних, оскільки інфекція може призвести до ускладнень, таких як передчасні пологи, інфекції сечовивідних шляхів або сепсис. Важливо вчасно виявити та лікувати стафілококову інфекцію для захисту матері та дитини.
Сучасні методи лікувати золотистого стафілококу
Лікування золотистого стафілококу залежить від типу інфекції та чутливості бактерії до антибіотиків. До основних методів лікування золотистого стафілококу належать:
- Ліки та антибіотики. Вибір антибіотика при золотистому стафілококу залежить від чутливості бактерії. Наприклад, стафілококовий анатоксин застосовується для профілактики та лікування інфекцій, спричинених стафілококом, шляхом формування імунітету проти його токсинів. Стафілококовий імуноглобулін містить антитіла до стафілокока і використовується для посилення імунної відповіді організму при тяжких стафілококових інфекціях.
- Локальне лікування. Для шкірних інфекцій застосовують місцеві антибіотики або антисептики
- Профілактика. Для запобігання повторним інфекціям лікар може призначити курс антибіотиків і рекомендації щодо дотримання правил особистої гігієни.
Також існує стафілококовий бактеріофаг — це вірус, який вибірково знищує стафілококові бактерії та використовується як ефективний засіб у лікуванні інфекцій, спричинених стафілококом.
Завдяки сучасним методам та лікам від стафілококу можна ефективно боротися з інфекціями, спричиненими бактерією і запобігти їх ускладненням.
Як уникнути зараження золотистим стафілококом? – поради для збереження Вашого здоров'я від ДІЛА
Зараженню золотистим стафілококом можна запобігти за допомогою простих, але ефективних дій. Ось кілька важливих порад для захисту вашого здоров’я:
- Часто мийте руки з милом і водою, особливо після контакту з іншими, відвідування громадських місць або перед їжею. Використовуйте антисептики для рук, якщо немає доступу до води та мила.
- Уникайте пошкоджень шкіри (порізів, подряпин), адже бактерія може потрапити через будь-яку рану. Вчасно обробляйте їх антисептиками, щоб запобігти зараженню.
- Не використовуйте чужі рушники, бритви для гоління, ножиці чи інші предмети особистої гігієни, які можуть контактувати зі шкірою.
- Уникайте контактів з інфікованими людьми.
- Слідкуйте за дотриманням температурного режиму при зберіганні та приготуванні їжі, завжди звертайте увагу на терміни придатності продуктів, ніколи не купляйте готову їжу в сумнівних точках продажу, які не мають дозволу на реалізацію харчової продукції.
- Якщо у вас є хронічні захворювання або ви маєте ослаблений імунітет, проходьте регулярні медичні обстеження та не затягуйте з лікуванням інфекцій.
- Зміцнюйте імунну систему правильним харчуванням, фізичною активністю, достатнім відпочинком тощо.
Не забувайте про прості кроки профілактики, які допоможуть вам уникнути зараження та подбати про своє здоровʼя.